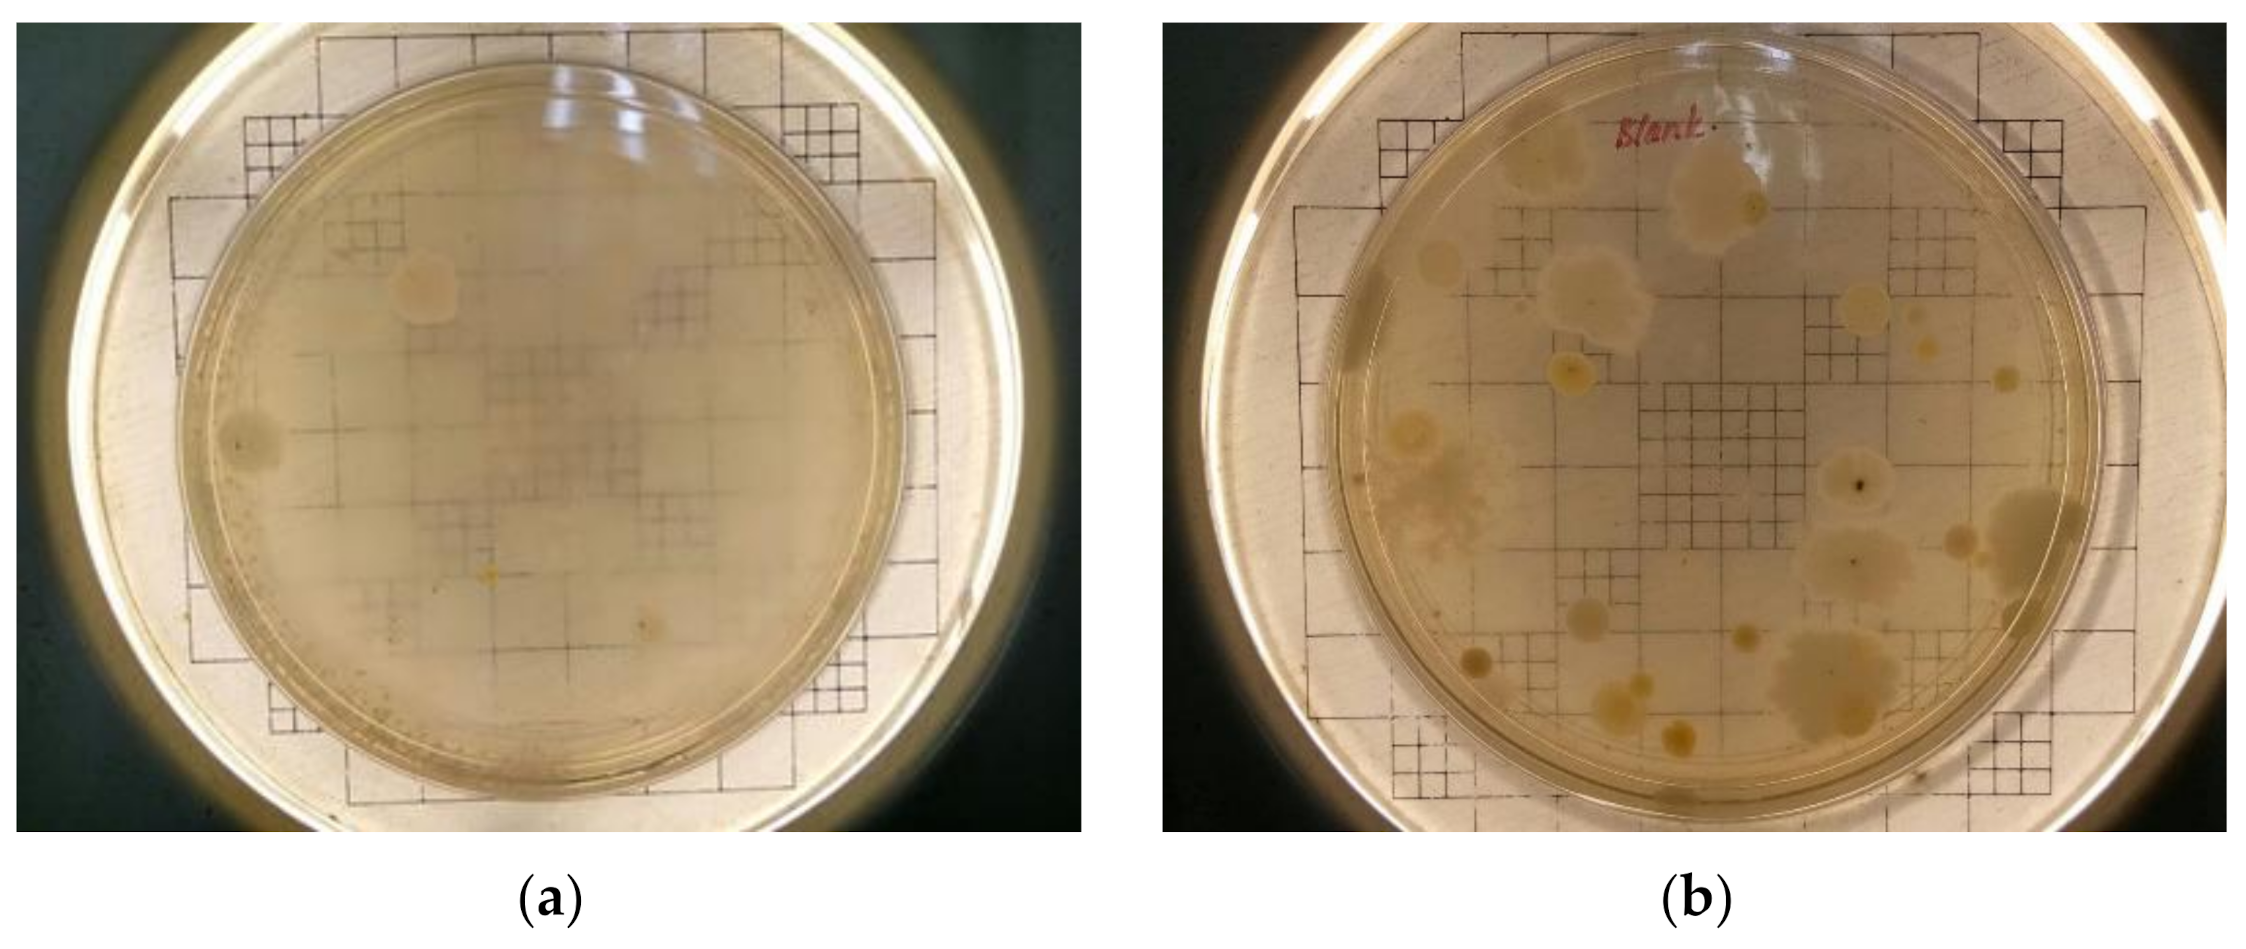
Ijerph 18 08192 g011a

Chemical, Biological and Morphological Properties of Fine Particles during Local Rice Straw Burning Activities
Abstract
:1. Introduction
2. Materials and Methods
2.1. Concentration of PM2.5 and Meteorological Data and Sample Collection
2.2. Physicochemical Analysis of Ambient PM2.5 Samples
2.3. Collection of Culturable Airborne Bacteria
2.3.1. Plating and Enrichment
2.3.2. DNA Barcoding
3. Results
3.1. The Concentration of PM2.5 during Rice Straw Burning Activities
3.2. The influence of Meteorological Conditions on PM2.5 Concentration
3.3. Morphological Properties of PM2.5 during Rice Straw Burning Activities
3.4. Variations of PM2.5 Trace Elements
3.5. Microbiol Composition Analysis
Bacteria Identification
4. Discussion
5. Conclusions
Author Contributions
Funding
Institutional Review Board Statement
Informed Consent Statement
Acknowledgments
Conflicts of Interest
References
- Yadav, I.C.; Devi, N.L. Biomass Burning, Regional Air Quality, and Climate Change. In Encyclopedia of Environmental Health; Nriagu, J., Ed.; Elsevier: Waltham, MA, USA, 2019; pp. 386–391. [Google Scholar] [CrossRef]
- Yin, S.; Wang, X.; Zhang, X.; Guo, M.; Miura, M.; Xiao, Y. Influence of biomass burning on local air pollution in mainland Southeast Asia from 2001 to 2016. Environ. Pollut. 2019, 254, 112949. [Google Scholar] [CrossRef] [PubMed]
- Phairuang, W.; Hata, M.; Furuuchi, M. Influence of agricultural activities, forest fires and agro-industries on air quality in Thailand. J. Environ. Sci. 2017, 52, 85–97. [Google Scholar] [CrossRef] [PubMed]
- Mueller, W.; Loh, M.; Vardoulakis, S.; Johnston, H.J.; Steinle, S.; Precha, N.; Kliengchuay, W.; Tantrakarnapa, K.; Cherrie, J. Ambient particulate matter and biomass burning: An ecological time series study of respiratory and cardiovascular hospital visits in northern Thailand. Environ. Health 2020, 19, 1–12. [Google Scholar] [CrossRef] [PubMed]
- Amk, E.S. Environmental and Health Impact of Open Burning Rice Straw. Egypt. J. Occup. Med. 2020, 44, 679–708. [Google Scholar] [CrossRef]
- Oanh, N.T.K.; Ly, B.T.; Tipayarom, D.; Manandhar, B.R.; Prapat, P.; Simpson, C.; Liu, L.-J.S. Characterization of particulate matter emission from open burning of rice straw. Atmos. Environ. 2011, 45, 493–502. [Google Scholar] [CrossRef] [Green Version]
- Gadde, B.; Bonnet, S.; Menke, C.; Garivait, S. Air pollutant emissions from rice straw open field burning in India, Thailand and the Philippines. Environ. Pollut. 2009, 157, 1554–1558. [Google Scholar] [CrossRef]
- Tipayarom, D.; Oanh, N.T.K. Effects from open rice straw burning emission on air quality in the Bangkok metropolitan region. ScienceAsia 2007, 33, 339–345. [Google Scholar] [CrossRef]
- Zainol, R.M.; Rose, R.A.C.; Mapjabil, J.; Marzuki, M. The Potential of Rice Straw in Agricultural Activities in the MADA Region of Kedah, Malaysia. Int. J. Asian Soc. Sci. 2019, 9, 295–303. [Google Scholar] [CrossRef] [Green Version]
- Lee, B.U. Life Comes from the Air: A Short Review on Bioaerosol Control. Aerosol Air Qual. Res. 2011, 11, 921–927. [Google Scholar] [CrossRef] [Green Version]
- Madhwal, S.; Prabhu, V.; Sundriyal, S.; Shridhar, V. Ambient bioaerosol distribution and associated health risks at a high traffic density junction at Dehradun city, India. Environ. Monit. Assess. 2020, 192, 196. [Google Scholar] [CrossRef] [Green Version]
- Wei, M.; Li, M.; Xu, C.; Xu, P.; Liu, H. Pollution characteristics of bioaerosols in PM2.5 during the winter heating season in a coastal city of northern China. Environ. Sci. Pollut. Res. 2020, 27, 27750–27761. [Google Scholar] [CrossRef]
- Duquenne, P. On the Identification of Culturable Microorganisms for the Assessment of Biodiversity in Bioaerosols. Ann. Work. Expo. Health 2017, 62, 139–146. [Google Scholar] [CrossRef] [Green Version]
- BLAST. Basic Local Alignment Search Tool. Available online: https://blast.ncbi.nlm.nih.gov/Blast.cgi (accessed on 30 April 2021).
- Li, X.; Feng, Y.J.; Liang, H.Y. The Impact of Meteorological Factors on PM2.5 Variations in Hong Kong. IOP Conf. Ser. Earth Environ. Sci. 2017, 78, 012003. [Google Scholar] [CrossRef]
- Zhao, W.; Gao, B.; Liu, M.; Lu, Q.; Ma, S.-X.; Sun, J.-R.; Chen, L.-G.; Fan, S.-J. [Impact of Meteorological Factors on the Ozone Pollution in Hong Kong]. Ch. Environ. Sci. 2019, 40, 55–66. [Google Scholar] [CrossRef]
- Yin, Q.; Wang, J.; Hu, M.; Wong, H. Estimation of daily PM 2.5 concentration and its relationship with meteorological conditions in Beijing. J. Environ. Sci. 2016, 48, 161–168. [Google Scholar] [CrossRef]
- Tai, A.P.K.; Mickley, L.J.; Jacob, D.J. Correlations between fine particulate matter (PM2.5) and meteorological variables in the United States: Implications for the sensitivity of PM2.5 to climate change. Atmos. Environ. 2010, 44, 3976–3984. [Google Scholar] [CrossRef]
- Pu, W.-W.; Zhao, X.-J.; Zhang, X.-L.; Ma, Z.-Q. Effect of Meteorological Factors on PM2.5 during July to September of Beijing. Procedia Earth Planet. Sci. 2011, 2, 272–277. [Google Scholar] [CrossRef] [Green Version]
- Popescu, F.; Ionel, I. Anthropogenic Air Pollution Sources; Kumar, A., Ed.; IntechOpen: Rijeka, Croatia, 2010. [Google Scholar] [CrossRef] [Green Version]
- Gheorghe, I.F.; Ion, B. The Effects of Air Pollutants on Vegetation and the Role of Vegetation in Reducing Atmospheric Pollution; Khallaf, M.K., Ed.; IntechOpen: Rijeka, Croatia, 2011. [Google Scholar] [CrossRef] [Green Version]
- Chhabra, V.; Kumar, R. Role of zinc application on rice growth and yield. Plant Arch. 2018, 18, 1382–1384. [Google Scholar]
- Chaturvedi, P.; Shivaji, S. Exiguobacterium indicum sp. nov., a psychrophilic bacterium from the Hamta glacier of the Himalayan mountain ranges of India. Int. J. Syst. Evol. Microbiol. 2006, 56, 2765–2770. [Google Scholar] [CrossRef] [Green Version]
- Hwang, S.-K.; Back, C.-G.; Win, N.K.K.; Kim, M.K.; Kim, H.-D.; Kang, I.-K.; Lee, S.-C.; Jung, H.-Y. Occurrence of bacterial rot of onion caused by Bacillus amyloliquefaciens in Korea. J. Gen. Plant Pathol. 2012, 78, 227–232. [Google Scholar] [CrossRef]
- Widdel, F.; Kohring, G.-W.; Mayer, F. Studies on dissimilatory sulfate-reducing bacteria that decompose fatty acids. Arch. Microbiol. 1983, 134, 286–294. [Google Scholar] [CrossRef]
- Selvakumar, G.; Kundu, S.; Joshi, P.; Nazim, S.; Gupta, A.D.; Gupta, H.S. Growth promotion of wheat seedlings by Exiguobacterium acetylicum 1P (MTCC 8707) a cold tolerant bacterial strain from the Uttarakhand Himalayas. Indian J. Microbiol. 2009, 50, 50–56. [Google Scholar] [CrossRef] [Green Version]
- Coorevits, A.; Dinsdale, A.E.; Heyrman, J.; Schumann, P.; Van Landschoot, A.; Logan, N.A.; De Vos, P. Lysinibacillus macroides sp. nov., nom. rev. Int. J. Syst. Evol. Microbiol. 2012, 62, 1121–1127. [Google Scholar] [CrossRef] [Green Version]
- Liu, Y.; Du, J.; Lai, Q.; Zeng, R.; Ye, D.; Xu, J.; Shao, Z. Proposal of nine novel species of the Bacillus cereus group. Int. J. Syst. Evol. Microbiol. 2017, 67, 2499–2508. [Google Scholar] [CrossRef]
- Junpen, A.; Pansuk, J.; Kamnoet, O.; Cheewaphongphan, P.; Garivait, S. Emission of Air Pollutants from Rice Residue Open Burning in Thailand, 2018. Atmosphere 2018, 9, 449. [Google Scholar] [CrossRef] [Green Version]
- Liu, L.; Liu, Y.; Wen, W.; Liang, L.; Ma, X.; Jiao, J.; Guo, K. Source Identification of Trace Elements in PM2.5 at a Rural Site in the North China Plain. Atmosphere 2020, 11, 179. [Google Scholar] [CrossRef] [Green Version]
- Wang, J.; Hu, Z.; Chen, Y.; Chen, Z.; Xu, S. Contamination characteristics and possible sources of PM10 and PM2.5 in different functional areas of Shanghai, China. Atmos. Environ. 2013, 68, 221–229. [Google Scholar] [CrossRef]
- Yue, W.; Li, X.; Liu, J.; Li, Y.; Yu, X.; Deng, B.; Wan, T.; Zhang, G.; Huang, Y.; He, W.; et al. Characterization of PM2.5 in the ambient air of Shanghai city by analyzing individual particles. Sci. Total. Environ. 2006, 368, 916–925. [Google Scholar] [CrossRef]
- Li, X.; Wang, S.; Duan, L.; Hao, J.; Li, C.; Chen, Y.; Yang, L. Particulate and Trace Gas Emissions from Open Burning of Wheat Straw and Corn Stover in China. Environ. Sci. Technol. 2007, 41, 6052–6058. [Google Scholar] [CrossRef]
- Chen, X.; Wang, L.; Zhou, J.; Wu, H.; Li, D.; Cui, Y.; Lu, B. Exiguobacterium sp. A1b/GX59 isolated from a patient with community-acquired pneumonia and bacteremia: Genomic characterization and literature review. BMC Infect. Dis. 2017, 17, 1–7. [Google Scholar] [CrossRef] [Green Version]
- Pandey, N. Exiguobacterium. In Beneficial Microbes in Agro-Ecology; Elsevier: Amsterdam, The Netherlands, 2020; pp. 169–183. [Google Scholar]
- Drewnowska, J.M.; Stefanska, N.; Czerniecka, M.; Zambrowski, G.; Swiecicka, I. Potential Enterotoxicity of Phylogenetically Diverse Bacillus cereus Sensu Lato Soil Isolates from Different Geographical Locations. Appl. Environ. Microbiol. 2020, 86. [Google Scholar] [CrossRef] [PubMed] [Green Version]
- Shimizu, M.; Nusrat, A. Lysinibacillus Species: Their Potential as Effective Bioremediation, Biostimulant, and Biocontrol Agents. Rev. Agric. Sci. 2021. [Google Scholar] [CrossRef]

| Parameter | Site Category | Mean | Median | Standard Deviation | Minimum | Maximum |
|---|---|---|---|---|---|---|
| PM2.5 Conc. (µg/m3) | S1 (B) | 9.79 | 9.00 | 6.39 | 1 | 28 |
| S1 (BB) | 41.00 | 21.50 | 58.82 | 10 | 233 | |
| S2 (B) | 14.79 | 15 | 7.98 | 4 | 40 | |
| S2 (BB) | 65.33 | 9.5 | 175.10 | 4 | 645 | |
| T (°C) | S1 (B) | 30.34 | 31.20 | 2.67 | 23.70 | 34.60 |
| S1 (BB) | 30.61 | 30.35 | 2.73 | 24.20 | 35.50 | |
| S2 (B) | 29.30 | 28.90 | 2.97 | 24.00 | 35.80 | |
| S2 (BB) | 28.88 | 28.90 | 2.71 | 23.80 | 33.40 | |
| RH (%) | S1 (B) | 62.23 | 59.00 | 11.21 | 44 | 84 |
| S1 (BB) | 60.59 | 61.00 | 12.75 | 39 | 84 | |
| S2 (B) | 67.95 | 67.00 | 11.93 | 45 | 88 | |
| S2 (BB) | 67.44 | 67.50 | 9.97 | 50 | 86 | |
| WS (m/s) | S1 (B) | 0.81 | 0.40 | 0.69 | 0.30 | 3.30 |
| S1 (BB) | 0.64 | 0.40 | 0.50 | 0.30 | 2.70 | |
| S2 (B) | 0.34 | 0.30 | 0.18 | 0.30 | 2.00 | |
| S2 (BB) | 0.47 | 0.30 | 0.38 | 0.30 | 2.50 |
| Sample | Bacteria Identified in the Sample | Query Coverage (%) | Percent Identity (%) | Reference | NCBI Reference Sequence |
|---|---|---|---|---|---|
| 1 | Exiguobacterium indicum | 76 | 81.29 | Chaturvedi and Shivaji 2006 | NR_042347 |
| 2 | Bacillus amyloliquefaciens | 99 | 98.85 | Nishikawi et al. 2007 | NR_041455 |
| 3 | Desulfonema limicola str. Jadebusen | 82 | 70.74 | Fukui et al. 1999 | NR_044782 |
| 4 | Exiguobacterium acetylicum | 99 | 98.81 | Rodrigues et al. 2006 | NR_043479 |
| 5 | Lysinibacillus macroides | 99 | 98.55 | Heryman et al. 2005 | NR_114920 |
| 6 | Bacillus proteolyticus | 98 | 98.42 | Liu et al. 2017 | NR_157735 |
| Bacterial Identified in the Sample | Morphological Characteristics | Physiological Characteristics | Reference | |
|---|---|---|---|---|
| Colony Descriptions | Cell Features | Temperature Tolerance | ||
| Exiguobacterium indicum | 2–4 mm in diameter, round shape, yellowish orange, plating on nutrient agar plates and incubated at 22 °C for 3 days. | Gram-positive, motile, rod-shaped, non-spore-forming. | pH range: 6–10 (not grow at pH 4) Temperature range: 10–30 °C, optimum growth at 25 °C NaCl tolerance: 5–8%. | [23] |
| Bacillus amyloliquefaciens | Slightly raised, 0.58–0.65 × 92.7–3.9 µm in diameter, colonies were creamy-white and rough and grew rapidly on tryptic soy agar (TSA) at 30 °C after 24 h incubation. | Gram-positive, single, rod-shaped cells, slightly irregular. | N/A | [24] |
| Desulfonema limicola str. Jadebusen | Natural sea water medium was replaced with synthetic saltwater media. Grown at 28–30 °C | Gram-negative (although two strains-stained Gram-variable to Gram-positive Width x length of one cell (µm): (2.5–3 × 2.5–3.5), length of filaments (µm): 50–1000. | pH Range: 6.5–8.8, optimum at 7.6 Temperature range: 15–36 °C, optimum at 30 °C. The type of strain requires at least 12 g NaC1 and 2 g MgCl2 × 6H2O per 1 of culture medium for optimum growth and does not develop in freshwater medium. | [25] |
| Exiguobacterium acetylicum | Medium sized circular, slightly raised, yellow pigmented, smooth colonies of 4–6 mm diameter on nutrient agar at 15 °C after 3–4 days incubation | Gram-positive, short rods with scattered arrangement of cells. | pH range: 4 to 10 Temperature range: 4 to 42 °C, optimum 30 °C NaCl tolerance: 2 to 8% | [26] |
| Lysinibacillus macroides | Moist and loose texture, circular shape, cream colored, with irregular edges and glossy surfaces. 24–48 h incubation at 30 °C on TSA containing 5mg MnSO4 1-1, diameter after 24 h incubation 0.5–1.0 mm; reach 3.0–5.0 mm after 48 h. | Gram-positive and Gram-negative motile rod, spore-forming bacterium, Cell length 0.9–1.1 × 3.0–5.0 µm on plate cultures, but long filaments of 10–100 µm or more may be formed in broth cultures. | pH range: 7.0–9.0, optimum pH 8.0. Not growth at pH 6.0. Temperature range: 20 °C to 45 °C. NaCl tolerance: In the presence of 0% (w/v) NaCl and in up to 4% (w/v) NaCl, but not in 5% (w/v). | [27] |
| Bacillus proteolyticus | Milk white, circular, non-translucent, 2–3 mm in diameter after incubation at 32 °C for 48 h on Luria-Bertani medium | Gram-positive, anaerobic, and non-motile, rod shape, central elliptical endospore, 1.6–1.8 µm in width and 2.8–3.6 µm in length. | pH range: 5–10, optimum pH8 Temperature range: 10–39 °C, optimum 30 °C. NaCl tolerance: 0–9% (w/v), optimum 0–1%. | [28] |
Publisher’s Note: MDPI stays neutral with regard to jurisdictional claims in published maps and institutional affiliations. |
© 2021 by the authors. Licensee MDPI, Basel, Switzerland. This article is an open access article distributed under the terms and conditions of the Creative Commons Attribution (CC BY) license (https://creativecommons.org/licenses/by/4.0/).
Share and Cite
Ramli, N.A.; Md Yusof, N.F.F.; Zarkasi, K.Z.; Suroto, A. Chemical, Biological and Morphological Properties of Fine Particles during Local Rice Straw Burning Activities. Int. J. Environ. Res. Public Health 2021, 18, 8192. https://doi.org/10.3390/ijerph18158192
Ramli NA, Md Yusof NFF, Zarkasi KZ, Suroto A. Chemical, Biological and Morphological Properties of Fine Particles during Local Rice Straw Burning Activities. International Journal of Environmental Research and Public Health. 2021; 18(15):8192. https://doi.org/10.3390/ijerph18158192
Chicago/Turabian StyleRamli, Nur Amanina, Noor Faizah Fitri Md Yusof, Kamarul Zaman Zarkasi, and Azrin Suroto. 2021. "Chemical, Biological and Morphological Properties of Fine Particles during Local Rice Straw Burning Activities" International Journal of Environmental Research and Public Health 18, no. 15: 8192. https://doi.org/10.3390/ijerph18158192
APA StyleRamli, N. A., Md Yusof, N. F. F., Zarkasi, K. Z., & Suroto, A. (2021). Chemical, Biological and Morphological Properties of Fine Particles during Local Rice Straw Burning Activities. International Journal of Environmental Research and Public Health, 18(15), 8192. https://doi.org/10.3390/ijerph18158192






